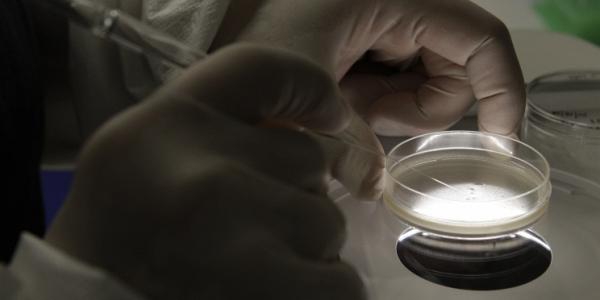

☎ +7 916 985-16-54
UNICLINICA пн-пт 8:00-20:00 мск, сб-вс 8:00-17:00 мск
☎ +7 916 985-16-54
UNICLINICA пн-пт 8:00-20:00 мск, сб-вс 8:00-17:00 мск
Бесплатная консультация уролога
Новый материал
- Арсенал новых средств против рака простаты
- Симптомы
-
Анатомия и физиология
- Эрекция
- Мастурбация
- Головка члена
- Крайняя плоть
- Лоханка почки
- Мастурбация
- Менструальный цикл
- Моча
- Мочевая система
- Мочевой пузырь
- Мочеточники
- Мошонка
- Мужские гормоны
- Мужские половые органы
- Нефрон
- Оплодотворение
- Паховый канал
- Половое созревание
- Половое созревание
- Половые гормоны
- Почки
- Предстательная железа
- Предстательная железа
- Придаток яичка
- Размер полового члена
- Семенной канатик
- Семявыбрасывающий проток
- Семявыбрасывающий проток
- Сперма
- Сперматогенез
- Сперматозоиды
- Старение у мужчин
- Уретра
- Эякуляция
- Эякуляция
- Детская урология
-
Урологические заболевания
- Простатит
- Аденома простаты
- Недержание мочи у женщин
- Опухоли почек
-
Рак почки
- Причины рака почки
- Симптомы рака почки
- Типы рака почек
- Стадии рака почки
- Диагностика рака почки
- Патоморфология рака почки
- Лечение рака почки
- Хирургическое лечение рака почки
- Что такое таргетная терапия
- Активное наблюдение при раке почки
- Биопсия рака почки
- Диагностика рака почки
- Консервативное лечение рака почки
- Лапароскопическая абляция рака почки
- Профилактика рака почки
- Стадии рака почки
- Рак простаты
- Рак мочевого пузыря
- Цистит
- Хронический пиелонефрит
- Нефроптоз
- Баланопостит
- Фимоз
- Водянка яичка
-
Бесплодие
- ЭКО, ИКСИ — вспомогательные репродуктивные технологии
-
Словарь терминов
- In vitro
- Агонист ГнРГ
- Азооспермия
- Азооспермия необструктивная
- Акне
- Акросома
- Амниоцентез
- Антагонист ГнРГ
- Антиспермальные антитела
- Антральные фолликулы
- Аспирация под контролем УЗИ
- Базальная температура
- Биопсия
- Биохимическая беременность
- Бластоциста
- Вазэктомия
- Варикоцеле
- Внематочная беременность
- Врожденный
- Вспомогательные технологии
- Вспомогательный хэтчинг
- Гидросальпинкс
- Гиперплазия эндометрия
- Гиперпролактинемия
- Гипертиреоз
- Гипотиреоз
- Гипофиз
- Гирсутизм
- Гистероскопия
- Гонадотропины
- Зона пеллюцида
- Индукция суперовуляции
- Инсеминация
- Интроцитоплазматическая инъекция сперматозоида
- Кариотипирование
- Клиническая беременность
- Кломифен цитрат
- Культивирование эмбриона
- Культуральная среда
- Лапароскопия
- Лютеинизирующий гормон
- Матка
- Маточные трубы
- Микроманипуляция
- Микрохирургическая аспирация сперматозоидов
- Мужской фактор бесплодия
- Муковисцидоз
- Обработка спермы
- Овариальный резерв
- Овуляция
- Оплодотворение
- Перенос гамет в фаллопиеву трубу
- Перенос зигот в фаллопиеву трубу
- Перенос эмбрионов
- Полип
- Преимплантационная генетическая диагностика
- Прогестерон
- Пронуклеус
- Пункция яичников
- Редукция многоплодной беременности
- Семявыносящие протоки
- Синдром гиперстимуляции яичников
- Синдром поликистозных яичников
- Сперматогенез
- Сперматозоиды
- Суррогатная мать
- УЗИ
- Фаллопиевы трубы
- Фертильность
- Фолликул
- Фолликулостимулирующий гормон
- Хламидиоз
- Цервикальная слизь
- Цервикальный канал
- Человеческий менопаузальный гонадотропин
- Чрескожная аспирация сперматозоидов
- Шейка матки
- Экстракорпоральное оплодотворение (ЭКО)
- Экстракция сперматозоидов яичка
- Эмболизация
- Эмбрион
- Эндометриоз
- Эстрогены
- Яичники
- Яйцеклетка
- Вазэктомия
-
Вопросы и ответы
- 1. Общие вопросы
- 2. Вопросы об эффективности вспомогательных репродуктивных технологий
- 3. Вопросы о различных факторах времени
- 4. Вопросы о результатах анализов
- 5. Вопросы о ходе лечения
- 6. Вопросы, касающиеся симптомов или проблем в текущем лечебном цикле
- 7. Вопросы о мерах предосторожности в период лечения
- Тестостерон
- Импотенция
- Киста яичка
- Болезнь Пейрони
- Трихомониаз
- Хламидиоз
- ВПЧ
- Варикоцеле
- Короткая уздечка
- Острые заболевания яичка
- Абсцесс почки
- Азооспермия
- Аногенитальные бородавки
- Аномалии почек
- Аспермия
- Астеноспермия
- Воспаление мочевого пузыря
- Генитальный герпес
- Гидронефроз
- Гидроцеле
- Гиперактивный мочевой пузырь
- Гипоспадия
- Дивертикул мочевого пузыря
- Доброкачественная гиперплазия предстательной железы
- Задержка мочи
- ИППП
- Инфаркт почки
- Искривление полового члена
- Камни почек
- Кондиломы
- Крипторхизм
- Меатостеноз
- Мегауретер
- Микоплазменная инфекция
- Мужское бесплодие
- Недержание мочи у мужчин
- Нейрогенный мочевой пузырь
- Некрозооспермия
- Нефролитиаз (мочекаменная болезнь)
- Олигоспермия
- Онкоурология
- Опухоль Вильмса
- Опущение почки
- Орхит
- Осложнения задержки мочи
- Парафимоз
- Перекрут яичка
- Перелом и травма полового члена
- Перламутровые (жемчужные) папулы полового члена
- Пиелонефрит
- Подковообразная почка
- Почечная недостаточность
- Преждевременная эякуляция
- Простая киста почки
- Пузырно-мочеточниковый рефлюкс
- Разрыв мочевого пузыря
- Рак полового члена
- Рак уретры
- Рак яичка
- Раннее половое созревание
- Свищ мочевого пузыря
- Синдром хронической тазовой боли
- Сифилис
- Сперматоцеле
- Стриктура уретры
- Травма половых органов
- Травма почки
- Травма уретры
- Травма яичка
- Туберкулез мочевого пузыря
- Туберкулез мочеполовой системы
- Туберкулез почки
- Туберкулез простаты
- Туберкулез яичка
- Уретероцеле
- Уретероцеле
- Уретрит
- Хроническая болезнь почек
- Цистоцеле
- Частое мочеиспускание
- Частое мочеиспускание
- Экстрофия мочевого пузыря
- Эктопия мочеточника
- Эктопия почек
- Эпидидимит
- Эписпадия
- Эректильная дисфункция
-
Диагностика в урологии
- УЗИ мочевого пузыря
- Внутривенная урография
- Сцинтиграфия почек
- Цистоскопия
- Анализ суточной мочи (суточный диурез)
- Бактерии в моче
- Белок в моче
- Биопсия почек
- Биопсия яичка
- Биохимия крови
- Биохимия мочи
- Боль в половом члене
- Гонококки
- Диагностика задержки мочи
- Доплер УЗИ
- Исследование предстательной железы
- Компьютерная томография
- Компьютерная томография почек
- Креатинин
- Лейкоциты в моче
- МРТ простаты
- Мочевина
- Обследование в урологии
- Общий анализ крови
- Определение химического состава камня
- ПСА (простат-специфический антиген)
- ПЭТ / КТ
- Пиелография
- Посев мочи
- Ретроградная уретрография
- Спермограмма
- ТРУЗИ
- Тестостерон
- Трепонема
- УЗИ органов мошонки
- УЗИ почек
- УЗИ простаты
- Уретроскопия
- Урография
- Урофлоуметрия (УФМ)
- Цистография
- Цистометрия
- Цитология мочи
-
Лечение
- Вазэктомия
- Литотрипсия
- Пересадка почки
- Увеличение члена
- Высокотехнологичная помощь в урологии
- Мочевые катетеры
- Стенты в урологии
- Поликистоз почек
- Восстановление крайней плоти
- Гемодиализ
- Лапароскопическая циторедуктивная нефрэктомия
- Лапароскопические операции
- Лапароскопия в урологии
- Лечение задержки мочи
- Лечение кисты почки
- Лечение недержания мочи у мужчин
- Нефростома: руководство по уходу для пациентов
- Орхиэктомия
- Открытая нефрэктомия с пластикой полой вены
- Открытая радикальная нефрэктомия
- Открытая резекция почки
- Открытая циторедуктивная нефрэктомия
- Перитонеальный диализ
- После радикальной простатэктомии
- ТУР простаты (трансуретральная резекция предстательной железы)
- Трансплантация почки
- Трансуретральная резекция предстательной железы (ТУР простаты) – восстановление и выписка
- Троакарная цистостомия
- Удаление кисты почки
- Уростома
- Уход за надлобковым катетером
- Цистостома
-
Что такое лапароскопия
- Возможности лапароскопии при гидронефрозе
- Лапароскопическая марсупиализация кисты почки
- Лапароскопическая нефрэктомия (лапароскопическое удаление почки)
- Лапароскопическая пластика при гидронефрозе
- Лапароскопическая радикальная нефрэктомия
- Лапароскопическая резекция почки
- Лапароскопическая резекция почки
- Лапароскопическая резекция почки
- Лапароскопическое удаление камня почки
- Лапароскопическое удаление опухоли с использованием аблации
- Лапароскопия
- Лапароскопия кисты почки
- Лапароскопия почки
- Лапароскопия при гидронефрозе
- Методика и инструменты для лапароскопии почек
- Осложнения лапароскопии
- Подготовка к лапароскопии
- После лапароскопии
- Сенсационный опыт удаления рака почки без единого кожного разреза
- Эпицистостомия
- Урологические препараты
- Аденомэктомия
- Анализ мочи
- Кавернит
- Мочекаменная болезнь
- Мочеприемники
- УЗИ мочевого пузыря — ультразвуковое исследование мочевого пузыря
- Урогинеколог
- Урологические клиники
- О нас
Новости
В нынешнем году электронные медицинские карты д
74 % врачей придерживаются мнения, что действующ
Ученые томского НИИ медицинской генетики первым
Пациентов с благоприятным прогнозом при раке пр
Экспериментальный иммунотерапевтический препарат
Московские медработники в скором времени станут
Малоподвижный образ жизни может привести к разви